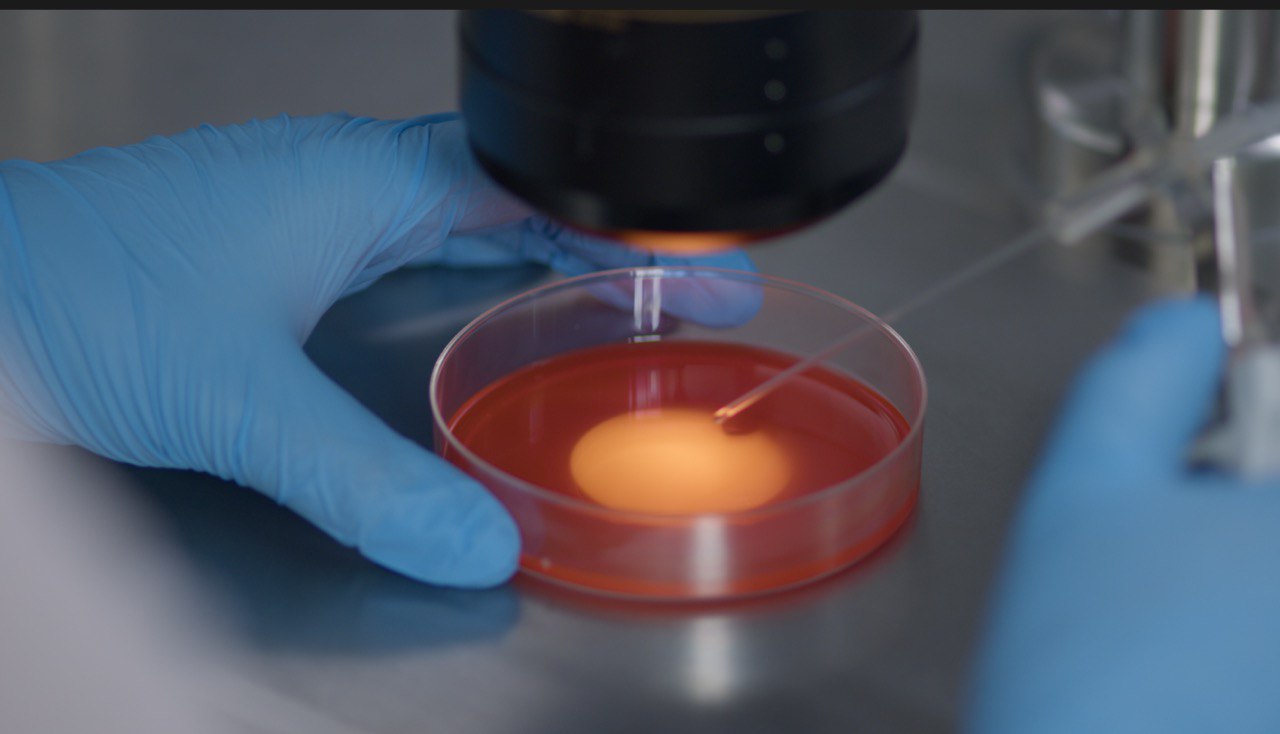

Нас окружает много рекламы, которая обещает ранее невозможное: «хочешь родить в 45+ — не проблема», «заморозь яйцеклетки — и все получится», «одно ЭКО — и ребенок у вас дома». Это соблазнительная идея, потому что она дает чувство контроля над самым интимным и важным в жизни человека — возможностью стать родителем. Я задумалась — действительно ли вспомогательные репродуктивные технологии (ВРТ) настолько всемогущи?
Чем больше я углублялась в этот вопрос, разговаривала с врачами и пациентами, тем яснее понимала: да, возможности у них огромные. Сегодня медицина умеет помогать там, где еще двадцать лет назад «ставили точку». Но вместе с тем есть факторы, о которых нельзя забывать. Вспомогательные репродуктивные технологии не отменяют ни возраст, ни состояние здоровья, ни качество самой программы ЭКО.
Я встречала пары, для которых каждая неудачная попытка ЭКО становилась не просто медицинским, а эмоциональным ударом, настоящей драмой. Одни семьи тратили годы и средства, а в паузы между циклами словно не жили. Другие сходили с дистанции, так и не дождавшись положительного результата. В этих историях есть и боль, и надежда, и та самая «цена времени», которую каждый решает платить по-своему.
Чтобы дать людям реалистичные ориентиры, необходим честный разговор с профессионалами. Я поговорила с Павлом Базановым, врачом-гинекологом-репродуктологом с 25-летним опытом, медицинским директором и главным репродуктологом клиники современных репродуктивных технологий, кандидатом медицинских наук.
Доктор Базанов говорит: «Когда ко мне приходит женщина около сорока и признается: «Павел Александрович, мне кажется, я уже опоздала», — это не абстрактная фраза, а отражение реального страха. За последние десятилетия репродуктивные технологии сделали огромный рывок. Благодаря им тысячи семей обрели детей. Но они остаются инструментом, а не магией. Медицина не создает жизнь из ничего. Она лишь помогают природе там, где естественный путь затруднен или невозможен».
Ограничения возраста, мужской и женский фактор
Разговор с доктором Базановым мы начали с самого очевидного вопроса — возраста. Ведь именно он чаще всего становится главным барьером на пути к родительству. Павел Александрович говорит: «Женщина может быть здорова, но если ей 42 — это уже совсем другие шансы, чем в 32. Медицина пока не умеет отменять время, возраст остается главным фактором успеха в зачатии. Чем старше женщина, тем меньше у нее качественных яйцеклеток, тем «слабее» ее гормональный фон. Уже после 30 лет вероятность естественного зачатия снижается, а в районе 40 резко падает».
Да, исследования подтверждают: если яйцеклетки криоконсервируются до 35 лет, вероятность рождения ребенка в будущем может составлять 52–69 %, в 38–40 лет —20–26 %, а после 42 лет — 10–15 %. Эти цифры не для того, чтобы пугать, а чтобы показать, что биология накладывает свои ограничения. Позднее материнство сегодня возможно массово. В практике таких историй немало. Но чем выше возраст, тем больше ресурсов, циклов и эмоциональных сил требуется.
Важно учитывать и здоровье мужчины. «Очень часто ко мне приходит пара «лечить женщину», — рассказывает Павел Базанов. — Но почти в половине случаев причина связана именно с мужским фактором: низкая подвижность сперматозоидов, генетические нарушения, последствия образа жизни. В моей практике таких историй огромное количество. Чем раньше пара понимает, что проблема может быть не только у женщины, тем быстрее удается найти решение. Когда обследование мужчины откладывают на годы, это оборачивается потерянным временем и неудачными попытками. Современные методы позволяют работать даже с тяжелыми формами мужского бесплодия — от ИКСИ до генетической диагностики. Важно, чтобы диагностика проводилась сразу для обоих партнеров».
Новый социальный контракт: карьера и семья
Мы поговорили с Павлом Базановым и о том, почему сегодня всё больше женщин откладывают материнство. «Когда в кабинете мы начинаем разговор о причинах, чаще всего речь идет не о «капризе» или «эгоизме», как это любят писать в комментариях в соцсетях. Настоящие причины в том, что нужно время, чтобы получить образование, построить карьеру, встретить надёжного партнёра, создать финансовую стабильность», — объясняет Павел Базанов.
Исследования подтверждают этот сдвиг: почти 70% женщин называют карьеру и образование главной причиной откладывания материнства, более 60% отмечают, что заморозка яйцеклеток позволяет им «сфокусироваться на профессиональных целях без чувства вины». Отложенное материнство — общемировая тенденция. В Европе и США средний возраст женщин, обращающихся за криоконсервацией яйцеклеток по социальным показаниям, составляет 37-38 лет, и только около 15 % делают это до 35 лет, когда шансы на успех наиболее высоки. «В России же большинство пациенток приходят к репродуктологу поздно, уже со сниженным овариальным резервом. Это значит, что шансы на успешное ЭКО в будущем ниже», — с сожалением говорит Павел Александрович.
Донорство, суррогатное материнство и страх «не своей генетики»
«Один из самых трудных разговоров с пациентами — не о том, как проходит ЭКО или какие лекарства нужны, а об использовании донорских яйцеклеток, — рассказывает Павел Александрович. — «Доктор, а будет ли этот ребенок моим?», — этот вопрос я слышал сотни раз, за ним стоит глубинный страх не полюбить «чужого» ребенка».
Эти тревоги не уникальны для России. В других странах страх «не своей генетики» также один из главных барьеров для принятия донорских программ. Общество все еще держится за мнение, что биология и родительство должны совпадать.
«Донорские эмбрионы используются для зачатия в ситуациях, когда будущие родители не имеют собственных качественных репродуктивных клеток или имеют серьезные заболевания, например, генетические. В моей практике множество историй, когда до беременности женщина сомневалась, а после родов говорила: «Это мой ребенок с первой минуты», — добавляет врач.
Суррогатное материнство — вторая непростая тема. Оно становится выходом тогда, когда будущая мама не может сама выносить малыша – по состоянию здоровья или другим причинам. Юридически разрешенное в России, оно остается в серой зоне общественного восприятия. Часто родители сталкиваются с осуждением, а суррогатные матери — с предвзятым отношением. Между тем для некоторых пар это единственный шанс на ребенка. Например, при тяжелых заболеваниях матки, удалении органов, угрозе жизни при беременности.
Факторы успеха ЭКО
Возраст и здоровье — это только одна сторона вопроса. Другая — качество самой программы ЭКО. Мы поговорили с доктором и о том, почему у одной и той же женщины результат в разных клиниках может быть совершенно разным. Оказывается, успех зависит не только от организма, а и от качества работы лаборатории, где работают с эмбрионами, протоколов стимуляции, опыта команды врачей. Малейшая неточность в дозировках или выборе времени переноса может определить исход цикла. Иногда решают часы и даже минуты. Любое отклонение от оптимального протокола снижает шансы на беременность и оборачивается новыми месяцами ожиданий, дополнительными расходами и эмоциональными испытаниями.
Чтобы минимизировать эти риски, в ведущих мировых клиниках репродукции в последние несколько лет используется специализированный цифровой сервис. «ИИ-платформа проводит глубокий анализ эффективности всех программ вспомогательных репродуктивных технологий и помогает обеспечить максимально высокие и предсказуемые результаты для каждой пары. В нашей клинике мы тоже ее сейчас внедряем. ИИ в режиме реального времени анализирует множество параметров, отслеживает динамику ответа яичников на стимуляцию и гормональный профиль, предоставляя врачу детализированную аналитику. Платформа позволяет сравнивать результаты клиники с международными базами данных. Общий эффект от использования системы на основе ИИ позволяет улучшать результаты ЭКО-программ в среднем на 30%», — говорит Павел Александрович.
Демография и доступность ЭКО
Государство относит рождаемость к стратегическим приоритетам, но доступ к ВРТ в России пока недостаточен. По данным национального регистра ВРТ, доля детей, рожденных с помощью ЭКО и других технологий, у нас — менее 1%, тогда как, например, в скандинавских странах — до 4–5% всех новорожденных. Разрыв объясняется не медицинскими возможностями, они в России есть, а в большей мере доступностью.
Есть программы по ОМС, но они ограничены квотами, возрастом, числом попыток и, как правило, очередями на месяцы. В частном секторе главный барьер — стоимость: один цикл обходится в среднем 200–400 тыс. руб. без учета лекарств. К этому добавляются региональные различия: в Москве и Петербурге выбрать клинику проще, а для жителей малых городов к цене прибавляются дорога, проживание, вынужденный отпуск, порой «без содержания» — итоговая сумма растет, а вместе с ней и «цена времени».
А вместе с тем международные исследования показывают: инвестиции в ЭКО и криоконсервацию для государства не обуза, а вложение с высоким возвратом. По расчётам RAND, в Великобритании и Австралии каждый «ЭКО-ребенок» приносит бюджету налогов в несколько раз больше, чем стоила сама процедура. Если перевести эту логику на российские цифры, картина такая: средняя стоимость программы ЭКО — около 200 тыс. руб., а налоговый вклад одного россиянина за жизнь составляет 8–12 млн руб. То есть, каждый ребёнок, рождённый с помощью ВРТ, «возвращает» в бюджет в десятки раз больше вложений.
Послесловие
Мы привыкли к технологическим чудесам: телефон подскажет дорогу, приложение рассчитает калории, алгоритм предложит плейлист «под настроение». Но репродуктивные технологии — не сервис «по подписке» и не страховка от обстоятельств. Что они точно делают — так это расширяют горизонты выбора. Поэтому говорить о них важно без иллюзий и драматизма, как об инструменте. Тогда у людей будет меньше неоправданных надежд и больше объективных решений. Потому что родительство — не продукт лаборатории, а личная история, которая начинается с первого удачного УЗИ, первых толчков ребенка, с момента, когда мать и отец впервые берут малыша на руки. И какой бы путь к этому ни вел — естественный или с помощью ВРТ, — он всегда остается историей любви, надежды и веры в будущее.